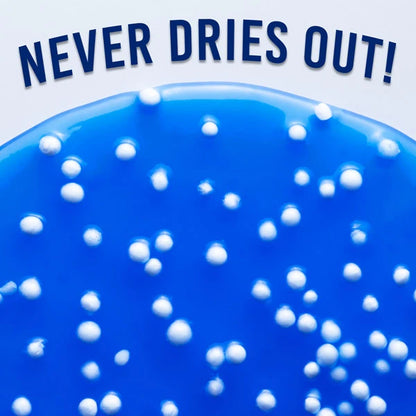
Crazy Aaron's Thinking Putty will never dry out -- even if forget to put it back in the tin.

1
/
of
10
Crackle’n Kracken Thinking Putty
Crackle’n Kracken Thinking Putty
Regular price
$14.95
Regular price
Sale price
$14.95
Unit price
/
per
FREE Shipping over $49.99 • $5.99 Flat Rate otherwise
Couldn't load pickup availability
Dive right into a sea of sensory bliss with Crackle'n Kraken Thinking Putty!
This super-satisfying addition to Crazy Aaron's already amazing lineup, is a tin of tactile goo with an ocean of sounds and feels that'll wrap its tentacles around your stress as gentle waves of calm wash over you.
Cracking open this putty's shell reveals a deep marine blue coloring, and a stress-easing ecosystem teeming with soft-white beads suspended within. So twist, tear, squeeze and stretch this pliable plaything to release the crackle'n for a snap and pop that never ends!
View full details
This super-satisfying addition to Crazy Aaron's already amazing lineup, is a tin of tactile goo with an ocean of sounds and feels that'll wrap its tentacles around your stress as gentle waves of calm wash over you.
Cracking open this putty's shell reveals a deep marine blue coloring, and a stress-easing ecosystem teeming with soft-white beads suspended within. So twist, tear, squeeze and stretch this pliable plaything to release the crackle'n for a snap and pop that never ends!